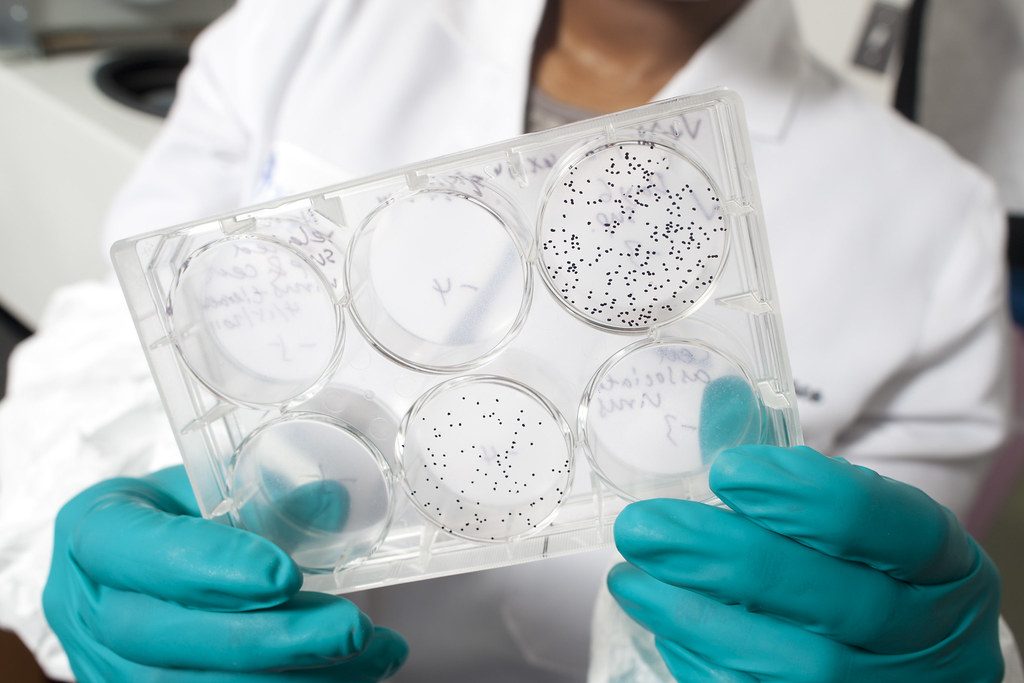

In 1984, the U.S. Health Secretary predicted an HIV vaccine within two years. Four decades and dozens of failed trials later, IAVI has begun dosing participants in South Africa with a vaccine built on an entirely different principle—one that attempts to train the immune system from the ground up rather than simply presenting it with viral proteins. The IAVI G004 trial, which began vaccinations in December 2025, represents the fourth step in a sequential vaccination strategy that has already demonstrated proof-of-concept in humans.
The approach matters because HIV mutates faster than any other virus, making traditional vaccine strategies inadequate. Previous trials achieved at best 31% efficacy (the 2009 Thai trial), and every large-scale efficacy trial since then has failed. This new germline-targeting strategy, developed by Scripps Research and IAVI, attempts to activate the rare B cells—perhaps one in 300,000—capable of eventually producing broadly neutralizing antibodies. Early trials have shown 94-97% of recipients develop the targeted immune response. But this scientific momentum collides with a funding crisis: NIH has announced it will end support for its major HIV vaccine consortia in 2026.